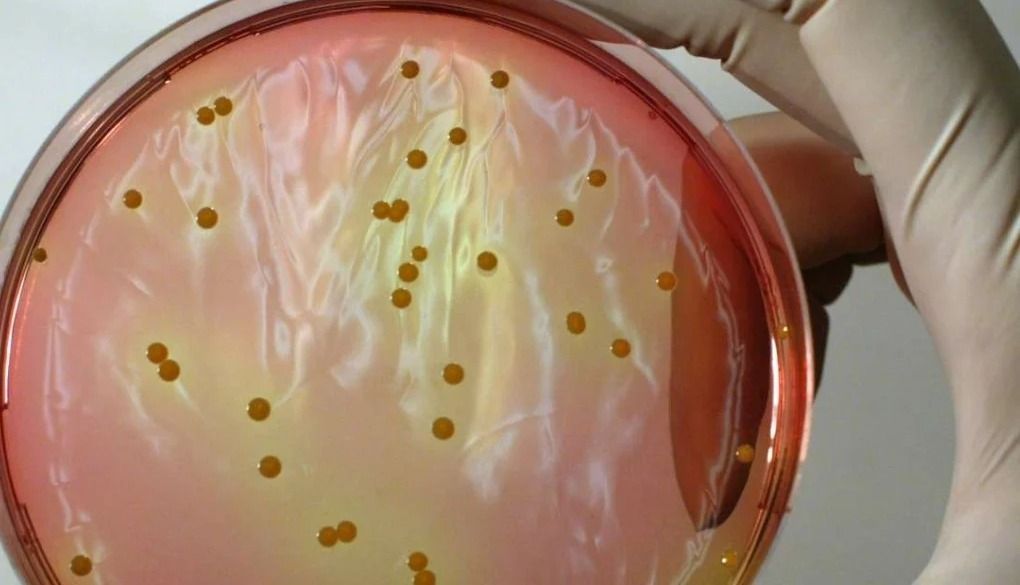
A szászrégeni házas emberek bálján felszolgált több étel is staphylococcusszal volt fertőzött

A szászrégeni házas emberek bálján felszolgált több étel, köztük a leves, a disznósajt, a sajt, a kolbász, a szalonna és a tepertő is koaguláz-pozitív staphylococcus baktériummal volt fertőzött – közölte február 13-án, csütörtökön a Maros Megyei Közegészségügyi Igazgatóság (DSP).
A rendezvény résztvevői közül közel negyvenen szorultak orvosi ellátásra szombat ételmérgezésre utaló tünetek miatt.
A Maros megyei DSP járványügyi vizsgálatot indított az eset után. Az intézmény tájékoztatása szerint 39 mintát vettek az eseményen felszolgált ételekből, a konyhai munkafelületekről és a személyzettől. Az élelmiszerekből vett négy mintában (leves, disznósajt, sajt, kolbász, szalonna, tepertő), a munkafelületekről vett két mintában és a személyzettől vett 12 mintában kimutatták a koaguláz-pozitív staphylococcus baktériumot, az egyik munkafelületről vett mintában pedig a kólibaktériumot is.
A járványügyi vizsgálat folytatódik, több minta elemzése is folyamatban van még. A konyha tevékenységét felfüggesztették, és 25 ezer lejes bírságot róttak ki az azt működtető cégre.
A közleményben arra is rámutattak, hogy a bál mintegy 350–400 résztvevője közül 37-en részesültek orvosi ellátásban a helyszínen vagy a sürgősségen.
Szerdán az Országos Állategészségügyi és Élelmiszer-biztonsági Hatóság (ANSVSA) arról tájékoztatott, hogy a bálon az előétel részeként felszolgált túró volt fertőzött koaguláz-pozitív staphylococcus baktériummal.